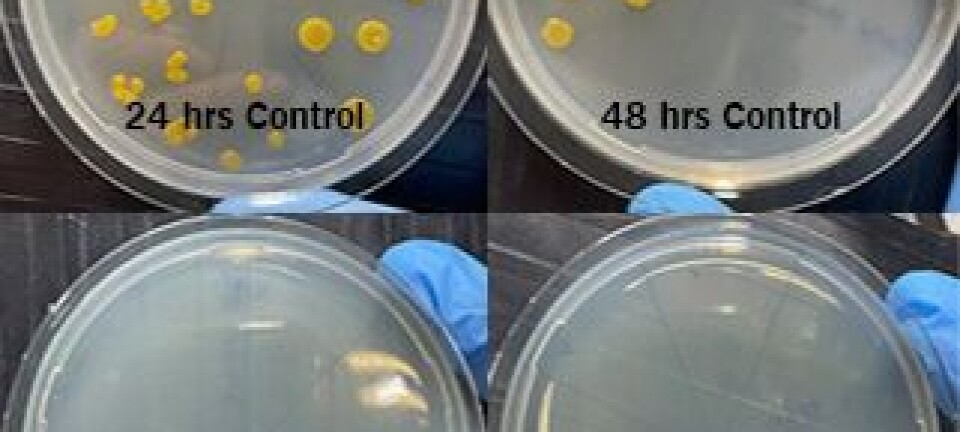

Holder groen borte uten impregnering. Oppdretter har kjøpt 150 nye notposer
Havforskningsinstituttet er bekymret for at kobber som faller av oppdrettsnøtene og ned på bunn under bruk skader livet i havet. En måte å unngå dette på er å benytte nøter der kobberet er bakt inn i fiberen. Garware som har utviklet fiberen, opplever nå stor kommersiell suksess med produktet.
Denne artikkelen er tre år eller eldre.
I forbindelse med at Havforskningsinstituttet i februar var ute med sin årlige risikorapport, løftet de opp problemstillingen med kobber.
Havforskeren hadde regnet på at en impregnert
sirkelmerd med diameter på 50 meter kan ha så mye som 400 kg kobber på seg. Noe
av kobberet «blør» ut fortløpende, mens de største utslippene skjer når noten
blir spylt ren.
- Ved første spyling kan i verste fall hele 80 kg bli spylt løst, sa Grøsvik.
Han var tydelig på at spyling med kraftig vannstråle er hovedutfordringen når det gjelder kobberutslipp:
– Hver gang en kobberimpregnert merd blir spylt så kommer det en kraftig puls med utslipp. Slike pulser bør vi unngå, sier han.
Samtidig påpekte han at etter at det har blitt mer fokus på utslipp av kobber de siste årene, har bruken av andre stoffer som tralopyril og sinkpyrithion har økt. Kunnskapen om miljøeffekten av disse stoffene er ifølge Grøsvik liten, og stoffene er kunnskapen om miljøeffekter liten, og han etterlyser riskovurderinger av dem, så de ikke blir nye miljøutfordringer.
Utviklet spesiell fiber
Forskerne ved utviklingsavdelingen til notfabrikanten Garware så imidlertid en mulig løsning på dette og klarte etter hvert å lage en HDPE(High Density Poly Ethylen)—tråd der metallisk kobber var innebygget i selve fibrene.

- Vi var i tidlig ute med nøter i HDPE som er et svært sterkt materiale. Fibrene er mye tykkere enn nylon og HDPE trekker ikke vann så posene tåler vasking og tøff behandling. Dermed beholdes styrken etter mange år i sjøen. De første HDPE posene var tykke med høy soliditet, men nå matcher de trådtykkelsen til impregnert nylon. Det forklarer Pål Korneliussen, som er landsjef for Garware i Norge.
- Vi fikk ideen om å ekstrudere inn metallisk kobber i våre HDPE nøter i 2016. Metallisk kobber er mye mindre giftig enn kobberoksid og er dermed mindre effektivt mot groe, men rent kobber har fortsatt god effekt. Vår ide var å låse kobberet inn i plastfibrene så det ikke kan falle av og synke ned på havbunnen og forurense sedimentene, sier han.
Dette var imidlertid ikke så enkelt som det høres ut da metallet er en urenhet som svekker styrken i tråden.
- Etter mye prøving og feiling klarte våre forskere å lage en sterk tråd i HDPE med en andel kobber inni. Denne kunne vi lage notposer, tau og luseskjørt av.
De første V2 notposene ble testet i sjø i Skottland i 2018. Korneliussen sier resultatene var svært lovende med redusert groe og mindre behov for vasking.
- Det var også tydelig at groen satt mindre fast og var lettere å spyle av i sjøen. Mindre vask betyr mindre forstyrrelser og urenheter inne i merden og bedre forhold for fisken. Dette er ikke minst viktig for gjellehelsen.
Man så tilsvarende resultater i Canada, men det var de Skotske kundene som viste mest interesse i starten.
40 % redusert vasking
Omtrent samtidig startet selskapet å markedsføre V2-posene i Norge.
Det store gjennombruddet i Norge kom etter at Salmar testet to V2 nøter sommeren 2019. De så en betydelig reduksjon i vasking i sjø sammenlignet med vanlig HDPE, med tilsvarende reduksjon i vaskekostnadene.
- Salmar var så fornøyde at de til nå har kjøpt over 150 V2 nøter fra Garware gjennom vår partner Selstad. Nøtene står i sjøen fra Smøla til Mehamn. Så vidt vi forstår kommer de til å fortsette å skifte ut sine gamle nøter med V2, sier han.
Disse notposene er ikke billige siden kobber er dyrt, men Salmar sier ifølge Korneliussen at de sparer dette inn i reduserte vaskekostnader.
- I snitt er vaskingen deres redusert med cirka 40% sammenlignet med vanlige HDPE nøter. Det utgjør en betydelig besparelse i kostnader.
Mindre behov for service
Servicestasjonene som har hatt V2 posene til service melder ifølge Korneliussen om betydelig mindre behov for reparasjoner av hull etc. enn hva de ser i tradisjonelle nylonposer.
- Noe maskebrudd er det alltid og uhell skjer selvsagt, men i gjennomsnitt sier de at HDPE trenger rundt en tredjedel av arbeidet til en nylonnot. Det utgjør også store besparelser for oppdretterne, sier han .
Han lovpriser oppdretternes vilje til å være innovative
- Det er fantastisk at norske oppdrettere er så villige til å teste ny teknologi og nye løsninger på utfordringene de måtte ha. Det er det som driver verden framover. I sum har vi nå levert cirka 400 av disse nøtene rundt i alle lakseregionene i verden, over halvparten har gått til Norge, sier han.